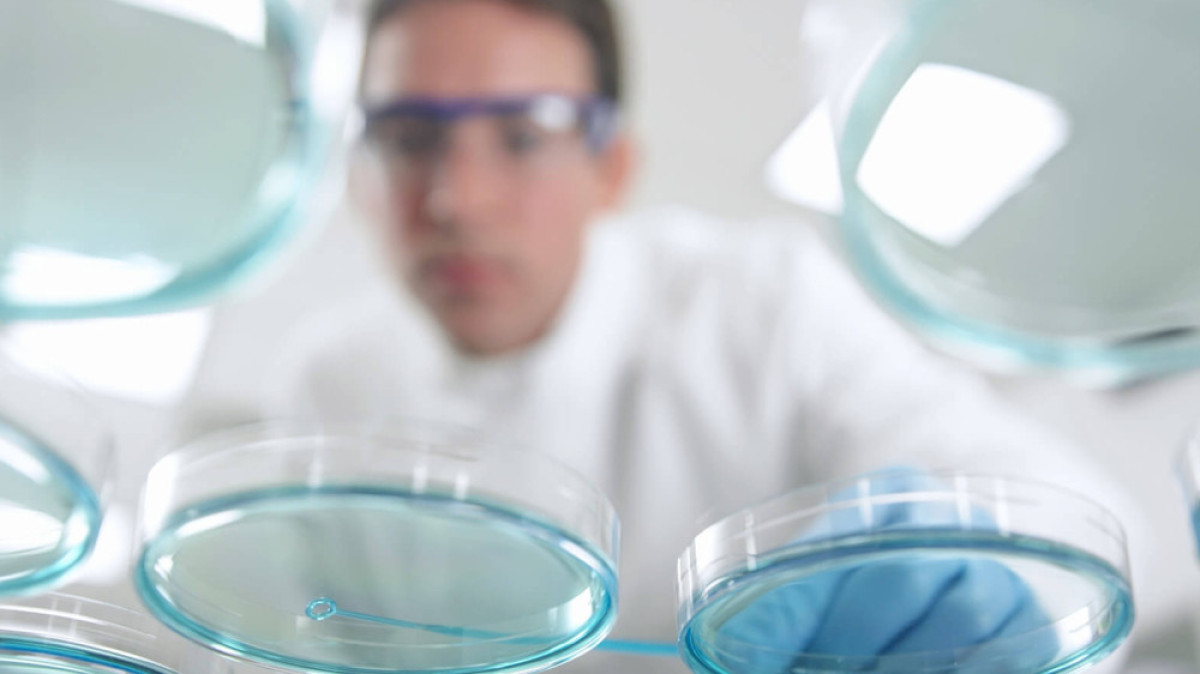
из открытых источников

Как можно удешевить стоимость ЭКО в Казахстане, рассказали врачи
<p>Сейчас стоимость ЭКО колеблется от 500 тысяч до 900 тысяч тенге, включая препараты. </p>
17 Января 2018, 19:18
17 Января 2018, 19:18
В Казахстане каждая пятая семейная пара имеет проблемы с зачатием ребенка. Об этом сообщил медицинский директор клиники "Экомед Астана", врач-репродуктолог Алмас Ибрагимов в ходе международной научно-практической конференции "Новое в репродуктивной медицине: малозатратное экстракорпоральное оплодотворение и сохранение фертильности у онкобольных", передает корреспондент BNews.kz.
"Бесплодие является актуальной проблемой современного мира. На данный момент более точной статистики нет. Это связано с анонимностью при обращении за такого рода услугами в платные учреждения. Бесплодие лечится очень долго, потому что не каждой женщине можно помочь за один месяц. Тем не менее, на сегодняшний день репродуктивная медицина в Казахстане находится на высоком уровне и соответствует европейским стандартам. За весь период запуска программы по репродуктивной медицине в Казахстане с 1996 года на свет появилось более 14 000 детей", - сообщил Ибрагимов.
По словам специалиста, к ЭКО прибегают не сразу: сначала применяют консервативное лечение, точнее могут направить на оперативное вмешательство, однако ЭКО самый эффективный из всех имеющихся методов на сегодняшний день. Одна попытка ЭКО даёт вероятность наступления беременности от 40 до 60%.
"Ежегодно государство выделяет определенное количество квот на ЭКО, но на сегодняшний день на все государство их не хватает. В этом году государство выделено 900 программ. Цена колеблется от 500 тысяч до 900 тысяч тенге, включая препараты. Большинство квот получают в Алматы и ЮКО. Возможно, если мы перейдем к страховой медицине, то она возможно будет покрывать расходы на ЭКО", - сказал эксперт.
Основатель и руководитель первой лаборатории ЭКО в Казахстане, научный директор сети клиник "Экомед" Салтанат Байкошкарова сообщила, что в Казахстане можно удешевить программу ЭКО путем расширения круга возможности без применения препаратов или с минимальным количеством препаратов, потому что препараты для гормональной стимуляции составляют почти 40-50% всей стоимости программы.
"Квоты выделяются в Казахстане с 2010 года. В этом году 900 квот, но тем не менее этих квот мало, их недостаточно, многие ждут их годами. Пока три года стоишь в очереди, твой репродуктивный возраст возрастает и шансы уменьшаются. Потом многие не могут идти даже по квоте на ЭКО. Особенно это касается молодых женщин, которым можно не давать много препаратов и быстрее добиться беременности. Это касается и старшей возрастной группы. Потому что сколько препаратов не давай, все равно получишь 1-2 фолликула вместо 10-15 ожидаемых. Поэтому затраты можно уменьшить за счет снижения затрат на препараты. Можно удешевить программу, сделать более доступной, потому что квотных программ в государсто все равно не хватает", - пояснила она.
Другими словами, если на одну квоту выделяется около 700 тысяч тенге, из них около 400-500 тысяч уходит на препараты.
Алмас Ибрагимов отметил, что все больше пар самого разного возраста обращаются в ЭКО-клиники.
"Если мы в 2010 году делали в день 15 циклов ЭКО, то сейчас 150 циклов, это очень хороший рост. Количество обращающихся, конечно, растет. Это не связано с темпами роста бесплодия, это связано с тем, что мы работаем плодотворно. В настоящее время у нас, кроме казахстанцев, большой поток людей с постсоветских стран - Узбекистана, Таджикистана, России, Германии, потому что стоимость программы ЭКО у нас дешевле", - сообщил эксперт.
Рост фактов бесплодия в Казахстане он связывает со сменой образа жизни современной молодежи. Большинство работают в офисах, питаются нездоровой пищей, получают стрессы. Влияет и плохая экология.
"Нельзя выделить единственный фактор, которого можно было избежать и улучшить ситуацию, потому что влияние многофакторное. Очень большие изменения, которые невозможно контролировать, и это происходит по всему миру", - сказал он.
К сожалению, как отметил Ибрагимов, чаще всего за услугами ЭКО обращаются люди в возрасте, потому что в свое время пары прибегают к иным методам лечения.
"Люди очень долго лечатся другими методами, по святым местам ходят и теряют очень много времени, поэтому чаще всего обращаются люди старше 35 лет. В последнее время заметная тенденция, что обращаются и молодые люди, а в молодом возрасте метод работает намного эффективнее, чем в старших возрастных группах. В 2010 годах всего 10-15% могли быть моложе 30 лет. На сегодняшний день таких 30-40%. Количество обращающихся в молодом возрасте растет, потому что понимают, что нет смысла очень долго лечить, тянуть и ждать", - отметил он.
ЭКО также может повлиять на здоровье женщины, однако эксперт утверждает, что если девушка обследована и у нее нет никаких противопоказаний, учтены все риски, то существенного влияния после ЭКО нет.
"Редкие случаи бывают, когда есть какие-либо осложнения. К сожалению, сейчас женщины в погоне за карьерой надолго откладывают беременность. Самый оптимальный период рождения детей - до 30 лет, дальше шансы все меньше и меньше. У мужчин достаточно долго сохраняется фертильность, но все равно до 35 лет очень желательно", - заявил он.
Доктор также сообщил, что в клинике в Астане по статистике каждый день рождается 1-2 ребенка. В месяц получается минимум 300-500 детей, потому что иногда бывают двойни.
Экстракорпоральное оплодотворение – вспомогательная репродуктивная технология, применяемая при бесплодии. По определению Всемирной организации здравоохранения (ВОЗ), бесплодный брак – это отсутствие беременности в течение одного года у супругов детородного возраста при условии, что они ведут регулярную половую жизнь без применения противозачаточных средств.
Самое читаемое
- На похоронах Али Хаменеи прозвучали призывы убить Трампа
- Штормовое предупреждение объявили по всему Казахстану на 7 июля
- В Алматы мужчина погиб после семейного конфликта
- Убийство 11-летней девочки вызвало массовые протесты во Франции
- Без компромиссов: почему Кремль не пойдет на переговоры до 2027 года

